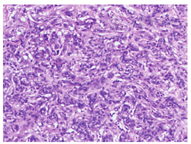

版权归中华医学会所有。
未经授权,不得转载、摘编本刊文章,不得使用本刊的版式设计。
除非特别声明,本刊刊出的所有文章不代表中华医学会和本刊编委会的观点。
乳腺癌是女性最常见的恶性肿瘤之一,呈逐年上升趋势,在我国占全身各种恶性肿瘤的7%~10%,目前已跃居我国女性恶性肿瘤发病率的第1位。乳腺癌的常见转移途径为局部蔓延、淋巴转移、血行转移,最常见的远处转移依次为骨、肺、肝。乳腺癌甲状腺转移发病率低、临床罕见,现将我院诊治的经手术切除、病理证实的乳腺癌双侧甲状腺转移一例报道如下,并结合相关文献复习该病的发病特点、诊断与鉴别、诊疗措施及预后。
患者女性,63岁,因颈部肿物伴声音嘶哑6个月入院。患者半年前即发现颈部侧前方两枚蚕豆大小肿物,伴声音嘶哑,无胸憋气短,肿物渐增大,并出现饮水呛咳、吞咽困难。体格检查:双侧甲状腺均可触及结节,左叶较大者约2 cm×3 cm,右叶较大者约2 cm×2 cm,质硬,边界不清,随吞咽移动不显著。双侧颈部可触及肿大淋巴结,左侧较大者约1 cm×2 cm,右侧较大者约1 cm×1 cm,颈部未闻及血管杂音。甲状腺球蛋白25.98 ng/ml,抗甲状腺球蛋白抗体15.2 IU/ml,抗甲状腺过氧化物酶抗体<5 IU/ml,促甲状腺激素受体抗体阴性。甲状腺核素显像示"冷结节"。彩超检查:双侧甲状腺不均质片状低回声区伴点状钙化,颈部大血管周围可探及多发肿大淋巴结,锁骨上窝、颌下未探及明显肿大淋巴结,考虑甲状腺癌伴颈部淋巴结转移。CT增强扫描:双侧甲状腺占位性病变,考虑甲状腺癌可能性大,颈部血管周围见肿大淋巴结。
既往史:患者4年前患"左侧乳腺癌",在我院行乳腺癌改良根治术。病理报告(图1):左乳腺浸润性导管癌,WHO Ⅱ级,肿瘤大小3.0 cm×2.0 cm×1.5 cm,乳头下和基底部未见癌组织,腋下淋巴结见癌组织转移(7/27)。免疫组化检测:ER(+,25%~50%), PR(+,<10%), Her-2(+), TOPO-Ⅱ(+,<5%), Ki-67(+,<10%), CK5/6(-), P120(+), E-cad(+), LRP(+++), P53(+,<25%), P63(-), β-catenin(+)。术后3周给予TE方案(表柔比星90 mg,第1天静脉滴注;紫杉醇210 mg,第2天静脉滴注)化疗4个周期,后采用6MV-X线放疗,左锁骨上、左腋窝垂直照射及左胸壁内外切线野照射各DT: 50 Gy/25F, 2 Gy/F qd,每周5次;放疗完毕后继续原方案静脉化疗2周期,放化疗结束后每半年复查一次。

完善术前准备后在插管全麻下行手术治疗,术中切除标本快速病理检查提示为恶性肿瘤,遂行"双侧甲状腺腺叶切除+峡部切除+功能性(Ⅱ~Ⅵ区)颈淋巴结清扫术",术中发现癌组织已突破甲状腺被膜,Ⅵ区、Ⅳ区、Ⅲ区、Ⅱ区均可触及大小不等肿大淋巴结,无粘连及融合,未侵犯颈部动静脉。术后恢复良好,无声嘶、抽搐、饮水呛咳等并发症。病理报告(图2):右侧甲状腺转移性腺癌,脉管内见癌栓;左侧甲状腺转移性腺癌,脉管内见癌栓。颈部淋巴结见癌组织转移:左侧Ⅵ区(4/4)、Ⅴ区(0/8)、Ⅱ区+Ⅲ区+Ⅳ区(6/13);右侧Ⅵ区(2/3)、Ⅴ区(0/5)、Ⅱ区+Ⅲ区+Ⅳ区(3/11)。免疫组化检测:ER(+,<25%),PR(+,>90%), Her-2(+++), TOPO-Ⅱ(+,<25%), Ki-67+(+,约25%),CD5/6(-), Tg(-), TTF-1(-), CD34(血管+), CK20(-), CK7(+), CK8(+), G-3(弱+)。病理组织学及免疫组化结果支持来源于乳腺,病情恢复后采用EC-TH方案静脉化疗(环磷酰胺+表柔比星4周期,再予多西他赛+曲妥珠单抗4周期,再单用曲妥珠单抗至1年),现已随访7个月,恢复良好。


据尸检资料报告,恶性肿瘤死亡患者中约9.5%存在甲状腺转移[1]。转移途径主要有3种:①局部直接蔓延扩散,如食管癌、咽喉癌等;②淋巴转移,可见于乳腺癌等;③血行转移,如肾癌、黑色素瘤、肺癌、肝癌、胆囊癌、卵巢癌、肉瘤等[2]。临床上,转移性甲状腺癌最常见的原发灶是肾母细胞癌,其次为黑色素瘤、肺癌、头颈部癌、淋巴瘤、白血病等。理论上讲,由于甲状腺血液循环非常丰富,通过血源性途径发生转移性甲状腺癌的概率理应较高,但实际临床中并不多见,原因可能与甲状腺缺乏过滤功能有关。原发性乳腺癌转移最常见的部位是淋巴结,其次是骨、肺、肝和脑,偶有消化道转移,发生甲状腺转移,尤其是双侧转移的概率极低,临床罕见[3]。
乳腺、甲状腺同属于下丘脑-垂体内分泌轴调节的激素靶器官,均受体内多种激素调节和控制,两器官癌灶的发生、发展与体内激素水平、内分泌功能变化具有密切关系。在乳腺癌的发生发展进程中,雌激素、孕激素、甲状腺激素是重要的促进因素,乳腺组织细胞癌变后仍具有激素受体功能,其原来所依赖的激素仍然调节着癌细胞生长[4]。研究表明,分化型甲状腺癌肿瘤直径及临床分期与促甲状腺激素浓度呈正相关,甲状腺激素受体与雌激素受体在核酸排列上存在着部分相似性,因此,两者在调节靶细胞生长过程中可能存在相似的通路[5]。
(1)乳腺与甲状腺多原发癌:多原发癌又称重复癌,是指同一宿主单个和(或)多个器官组织同时或先后发生2种或2种以上的原发性癌。其诊断标准主要有3点[6]: ①每个癌灶生长于不同部位;②每个癌灶都有确切独特的病理学证据;③排除复发癌和转移癌。两种癌诊断间隔<6个月为同时性多原发癌,>6个月为异时性多原发癌。在乳腺癌细胞中,甲状腺激素可模拟雌激素的作用,并在一定程度上与雌激素发生协同作用,增强雌激素效应;而在甲状腺癌细胞中,雌激素、孕激素的表达亦高于正常组织,血清游离T3、T4升高者乳腺癌发病风险亦明显升高。临床发现,先后罹患乳腺癌和甲状腺癌的患者比非癌患者具有较高的发病风险,提示这两种癌的发生可能与雌激素、孕激素、甲状腺激素存在一定关系[7,8]。
(2)乳腺癌之后发生转移性甲状腺癌:患乳腺癌之后发生甲状腺转移,可分为同时性和异时性2种情况,前者指发生原发性乳腺癌的同时即发生并发现转移性甲状腺癌,后者指发生原发性乳腺癌后数月或数年才发生并发现转移性甲状腺癌。本例属于后者,且大多数病例报道属于异时性转移癌。数十年来,对乳腺癌甲状腺转移的报道资料多来源于个案回顾性研究,缺少大样本前瞻性研究。
彩超检查无创、方便、费用低廉、无放射性损伤、重复性强,已成为甲状腺结节的首要影像学检查,是鉴别良恶性的重要技术手段,其声像图表现以下特征应高度怀疑为癌[9,10,11]: ①形态不规则,边界不清楚,质地不均匀;②实性低回声纵横比>1;③毛刺状或蟹足状伴细沙状、点状钙化灶;④淋巴结肿大,形态失常,长短比<2;⑤血流丰富,边缘缺乏血流信号。目前以彩超显示实性低回声、边界不清、纵横比>1、微小钙化等恶性特征为依据制定的甲状腺声像和数据报告系统,提高了诊断原发性甲状腺癌的可靠性[12]。一般认为,转移性甲状腺癌并无有别于原发性甲状腺癌的特异性声像图特征,其实验室检查亦无敏感性指标,甲状腺球蛋白、抗甲状腺球蛋白抗体、抗甲状腺过氧化物酶抗体、促甲状腺激素受体抗体、甲状腺微粒体抗体等指标均正常或不同程度升高,缺乏特异性。唯甲状腺球蛋白染色原发性甲状腺癌多呈阳性,转移性甲状腺癌则多呈阴性。确诊的最佳方法只能依赖穿刺活检或术后病理诊断。本例术前甲状腺功能各项指标均在正常范围,最终由术后病理组织学及免疫组化结果才获诊断。
转移性甲状腺癌临床表现无明显特征性,肿瘤较小时,无明显临床症状、不易察觉,仅仅依靠体格检查、实验室、影像学资料很难早期做出诊断,待其出现明显临床症状时,转移灶往往已较大,患者多以短期内甲状腺体积迅速增大,伴或不伴声音嘶哑及呼吸、吞咽困难为主要就诊原因;肿瘤侵犯神经可出现声音嘶哑、饮水呛咳,侵犯气管、食管会出现相应的梗阻症状。通过超声、核素扫描、细针穿刺活检等有助于诊断。乳腺癌患者发现甲状腺结节,活检组织免疫组化检测到甲状腺转录因子1和甲状腺球蛋白阳性,应考虑原发性甲状腺癌;检测到雌激素受体和孕激素受体阳性,应考虑转移性甲状腺癌。本例由于术前未行穿刺活检,体格检查、彩超、核素显像、CT检查等也未能发现乳腺癌甲状腺转移特征,考虑到患者有乳腺癌病史,甲状腺结节生长较快且已出现压迫症状,我们果断直接手术切除,解除了压迫。通过免疫组化检测ER(+)、PR(+)、TTF-1(-)、Tg(-),对乳腺癌甲状腺转移的诊断具有指导作用。另外,乳腺癌甲状腺转移还应与结节性甲状腺肿、桥本氏甲状腺炎、原发性甲状腺透明细胞癌等疾病鉴别[13]。
原发性甲状腺癌根据病理类型、侵犯范围不同,治疗方法亦不尽相同。分化型甲状腺癌选择甲状腺近全或全部切除。对颈部淋巴结无转移者,目前多不主张作预防性颈淋巴结清扫;但对已发生淋巴结转移者,可酌情选择功能性、选择性、根治性、扩大根治性以及改良根治性颈淋巴结清扫等,术后辅以放射性核素治疗和内分泌治疗,未分化型甲状腺癌则以放射治疗为主;原发性甲状腺癌对化疗不敏感,患者难以获益。转移性甲状腺癌的治疗应结合原发癌部位、临床分期、组织类型、转移灶大小、是否合并其他转移灶以及全身状态等因素综合考虑,治疗以手术切除为主,术后酌情采用化疗、放疗和内分泌治疗,对椎骨转移灶可行放射治疗。
生存期取决于乳腺原发癌的恶性程度以及转移早晚,相隔时间越短,预后越差。从临床确诊原发癌至出现甲状腺转移的时间大多为9个月~3年,如果得不到有效控制,生存期仅几个月,最终死于广泛播散。本例乳腺癌术后4年才发生甲状腺转移,且为双侧转移,行双侧转移性甲状腺癌切除+淋巴结清扫术,后按照"中国临床肿瘤学会乳腺癌诊疗指南"采取EC-TH方案化疗。就目前随访结果评价,患者总体获益。
总之,乳腺癌甲状腺转移发病率很低,极易漏诊误诊。既往有乳腺癌病史患者,随访中出现甲状腺结节,且短时间内迅速增大,应考虑到转移性甲状腺癌可能。术前联合应用彩超、核素显像、CT、甲状腺功能分析、细针穿刺活检及免疫组化,力争早期诊断、早期治疗。术后应根据多种因素制定合理的综合治疗方案,最大限度改善预后、延长生存期。





















